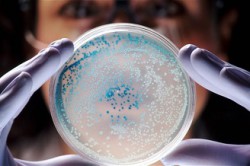
Исследование мужской семенной жидкости

Спермограмма — модное исследование. Даже те, кто только собирается в только будущем иметь детей, считают необходимым пройти такую проверку. Является ли практичным такой поступок или он только обычная дань новой моде? Насколько анализ помогает оплодотворению?
Краткого ответа не существует по нескольким причинам:
- спермограмма может меняться в зависимости не только от состояния мужчины, но и его настроения, психического настроя и даже тех продуктов, которые он ел за 3-4 дня до анализа;
- определение «качества» эякулята — только половина пути. ВОЗ считает, что спермограмма только на 50% подтверждает плодовитость (фертильность) мужчины;
- для того чтобы получить правильные выводы, нужно уметь читать полученные данные. Но даже точная расшифровка не дает полной гарантии, что мужчина сможет оплодотворить партнершу.
Более подробно о том, какую роль сперматограмма играет в жизни мужчины, как правильно расшифровывать ее и что делать в случае «плохих» результатов, мы и поговорим ниже. А пока — очень интересный факт. Если перевести генетическую информацию на более понятный сегодняшнему поколению «компьютерный» язык, то можно составить такую схему:
- любая человеческая клетка несет в себе 75 мегабайт информации;
- 1 сперматозоид — примерно 38 мегабайт информации;
- всего в 1 мм эякулята больше 100000000 сперматозоидов;
- выброс спермы во время оргазма длится не больше 5 секунд, причем за это время изливается около 2-4 мл спермы;
- проведя простой подсчет, получаем 1 687,5 терабайт в секунду. Именно такую DDoS-атаку выдерживает женская яйцеклетка во время мужского оргазма. Естественно, что она блокирует большую часть информации, принимая только один пакет. Однако его вполне достаточно для того, чтобы организм начал перезагрузку, которая будет длиться 9 месяцев и приведет к появлению нового организма.
Даже исходя из этого не самого серьезного примера, можно понять, что вязкость спермы, ее цвет, кислотность и прочие показатели весьма ограниченно влияют на возникновение беременности.
Несколько слов из истории
Сегодня слово «спермограмма» знакомо любому человеку. И многие знают, что сперматозоид — это такая «штучка с хвостиком», от которой зависит оплодотворение. Но далеко не всем известно, что Левенгук, который первым увидел под микроскопом странные хвостатые образования, принял их … за паразитов, поедающих сперму мужчины. Ему потребовалось много времени, чтобы понять, что спермии (так назвал Левенгук непонятные организмы) — это и есть зародыши будущей жизни. Однако он был уверен: это крошечные копии будущего новорожденного, которые не развиваются со временем, просто увеличиваются в размерах.
Только через 200 лет Гертвиг установил, что сперматозоид, проникая в яйцеклетку, оплодотворяет ее. Удивительные свойства сперматозоида были открыты еще позднее.
Каждый, кто собирается сегодня пройти спермограмму, должен знать:
длина среднестатистического мужского сперматозоида — 55 мкм;
- скорость движения — до 30 см в час;
- сперматозоид способен оплодотворить яйцеклетку даже через 72 часа, столько же времени он сохраняет свою подвижность;
- на протяжение всего 1 удара сердца в организме здорового мужчины образуется 15 000 спермиев.
Все эти сведения ученые приобрели в процессе изучения эякулята, который длился более 3-х веков. Однако только в 1929 году специалистам впервые пришло в голову изучить вероятность беременности в зависимости концентрации сперматозоидов в эякуляте. Спермограмма появилась еще позже.
Именно с этого времени стали проводить исследования, которые позволили связать концентрацию спермиев с фертильностью их обладателей, определить верхние и нижние границы этой концентрации. Но эти цифры постоянно уточнялись. Так сначала считалось, что, если в 1 мл эякулята меньше 60 млн спермиев, то мужчина не способен сделать женщину матерью. Потом это число снизилось до 40 млн.
Последние числовые уточнения были приняты ВОЗ в 2010 году. Именно их берут во внимание специалисты при расшифровке спермограммы. Что сегодня считают нормой?
- объем эякулята от 1,5 мл;
- не меньше 15 млн сперматозоидов в каждом миллилитре спермы;
- 40% и более подвижных сперматозоидов, из них не менее 32% должны активно двигаться вперед;
- не менее 4% спермий, имеющих нормальное морфологическое строение.
Из показателей видно: для того чтобы мужчина мог оплодотворить женщину, ему достаточно даже столь невысоких результатов.
Спермограмма является важным инструментом для оценки фертильности мужчин. Врачи подчеркивают, что этот анализ позволяет выявить множество факторов, влияющих на способность к зачатию. Качество спермы, включая количество, подвижность и морфологию сперматозоидов, играет ключевую роль в репродуктивном здоровье. Специалисты отмечают, что отклонения от нормы могут указывать на различные медицинские проблемы, такие как гормональные нарушения или инфекции. Кроме того, врачи акцентируют внимание на том, что регулярное обследование и анализы помогают выявить потенциальные риски и своевременно принять меры. Таким образом, спермограмма становится не только диагностическим инструментом, но и важным шагом на пути к успешному зачатию.
Что такое спермограмма?
Прежде чем пройти анализ на фертильность, мужчина должен понять:
любое исследование имеет погрешность не менее 5%. По этой причине единожды сданная сперматограмма не может приниматься во внимание, какие бы показатели в ней не были указаны. Для получения более или менее точных результатов будущий отец должен пройти исследование трижды;
- показатели вязкости, кислотности и т.п. зависят от многих факторов и могут меняться. Но об этом уже говорилось выше;
- психологический фактор — очень сильная составляющая, которая не отражается в результатах, но иногда влияет на фертильность даже больше, чем подвижность сперматозоидов, вязкость эякулята и т.д.
Так что же такое спермограмма? Это микро- и макроскопическое изучение эякулята. Под микроскопом специалисты изучают:
- клетки крови;
- клетки сперматогенеза;
- оценивают подвижность, строение и концентрацию сперматозоидов.
В макроскопическое исследование входят:
- оценка количества эякулята;
- его цвет;
- запах;
- уровень кислотности;
- консистенция и т.д.
Несколько последовательно проведенных спермограмм помогают не только определить фертильность мужчины в конкретный момент, но отследить изменение его сперматогенеза в ходе лечения.
Показатели спермограммы и их расшифровка
Спермограмма — это важный анализ, который позволяет оценить качество спермы и, соответственно, фертильность мужчины. Многие люди отмечают, что этот тест может быть источником как тревоги, так и надежды. Результаты спермограммы могут выявить различные проблемы, такие как низкое количество сперматозоидов или их малую подвижность, что может стать причиной бесплодия. Однако, несмотря на возможные негативные результаты, многие мужчины отмечают, что знание своего состояния позволяет им принимать меры для улучшения здоровья. Существуют различные факторы, влияющие на результаты, включая образ жизни, питание и стресс. Поэтому важно не только пройти анализ, но и обсудить его результаты с врачом, чтобы понять, какие шаги можно предпринять для повышения шансов на зачатие. В конечном итоге, спермограмма — это не только медицинский тест, но и возможность для мужчин лучше понять свое здоровье и фертильность.
Количество эякулята

- наличии инфекционных или воспалительных заболеваний;
- непроходимости семяпроводящих путей;
- недостаточно активном функционировании предстательной железы;
- неправильном развитии или строении пузырьков (семенных);
- ретроградной («обратной») эякуляции, при которой сперма, вместо того чтобы излиться наружу, попадает в мочевой пузырь4
- изменениях в организме из-за: ожирения, курения, алкоголя, недостатка движения и т.п.;
- недостаточно продолжительном периоде воздержания перед сбором эякулята.
Разжижение
Партнеры, занимающиеся сексом, замечали, что как только семя извергается наружу, оно становится студенистым. Это нормальный процесс, он называется коагуляцией. Уже через несколько минут при комнатной температуре эякулят «тает», превращаясь в жидкость. Этот процесс носит название разжижения и способен длиться 15-60 минут. Именно это время считается нормальным для разжижения.
Анализ проводят, подцепив на кончик стеклянной палочки или иглы каплю исследуемого материала. Затем иглу опускают вертикально и следят, как растягивается капля.
Анализ может показать, что в исследуемом эякуляте остаются «нерастаявшие» желеобразные гранулы. Это тоже считается нормальным и никак не влияет на общую клиническую картину и диагноз. Если процесс разжижение превышает 60 минут, это может указывать на недостаток ферментов или воспаление органов, ответственных за производство эякулята.
Вязкость, цвет и объем
Некоторые самоучки, пытаясь самостоятельно читать спермограмму, путают вязкость и разжижение.
Вязкость — это «густота» спермы. Чем гуще окружающая среда, тем труднее двигаться в ней любому организму. Чем выше вязкость спермы, тем сильнее она затрудняет продвижение сперматозоидов к желанной цели. Как определяют вязкость? Выпускают из пипетки или дозатора каплю принесенного на исследование эякулята. Капля не падает свободно (нормальная вязкость) или растягивается, превращаясь в нить. Последнее свидетельствует о том, что в организме мужчины происходит воспалительный процесс.

- если сперма окрашивается в розоватый цвет, это обозначает, что в сперме присутствуют эритроциты (кровь). Такое случается при некоторых формах простатита, травмах, везикулите;
- наличие желтых или коричневых оттенков в сперме заставляет задуматься о наличии в ней гноя или излишнем потреблении мужчиной продуктов, содержащих красители.
Что входит в эякулят? Секреты (вещества) которые производят разные мужские железы. Больше всего в сперме «продукта», который вырабатывают простата и пузырьки (везикулы). Еще в «коктейле» есть производное луковично-уретральных желез, эпидидимиса. Рассчитав содержание каждого элемента в сданном объеме спермы, можно почти точно вычислить, сколько сперматозоидов находится в нем и насколько это количество соответствует общепризнанной норме.
Кислотность спермы и другие показатели

- у мужчины имеет место быть обструкция путей, по которым продвигается семя;
- в эякуляте присутствует моча;
- семенные пузырьки недоразвиты и т.д.
Показатель больше 8 свидетельствует о высокой щелочности спермы из-за инфекций или воспалений в семяпроводящих путях.
Агглютинация — хорошо или плохо?
Агглютинация — это склеивание. Иногда сперматозоиды слепляются головками, хвостиками, либо головки одних прилипают к хвостикам других (смешанный тип). Такого в норме быть не должно. Если сперматозоиды слиплись, это свидетельствует о том, что на них «налипли» антитела или человек бесплоден по другим причинам. Агглютинация может быть:
- истинной, при которой спермии склеиваются между собой;
- ложной, когда они слепляются с другими клетками, содержащимися в сперме.
Причиной агглютинации, кроме болезней, может стать хирургическая операция, травма.
Что еще есть в сперме и сколько этого должно быть?

- лейкоциты (1×106 млн/мл). Если белых кровяных телец больше, это может означать наличие самых разных воспалений в организме;
- продукты сперматогенеза: круглые незрелые клетки. Их должно быть примерно 4 в поле зрения исследователя. Если их меньше, возможно у мужчины повреждены или плохо функционируют тестикулы;
- частички эпидермиса.
Концентрация сперматозоидов
Ее нельзя путать с общим количеством этих элементов.
Число сперматозоидов, которое входит в сданный эякулят, называется количеством и в норме составляет около 15 млн/мл и выше.
Разобраться в тонкостях этих соотношений способен только специалист, поэтому обычным пациентам лучше просто запомнить эти цифры. Более низкие показатели значительно уменьшают вероятность наступления оплодотворения (беременности).
Несколько слов о подвижности сперматозоидов. Они разделяются на 3 группы, каждая из которых имеет свои характеристики.
- неподвижные. Полное отсутствие движения свидетельствует о том, что эти организмы мертвы. Беременность наступить не может;
- непрогрессивно-подвижные. Это сперматозоиды, которые, активно «шевелясь» на одном месте, вперед не продвигаются. Они есть в сперме каждого мужчины;
- прогрессивно-подвижные. Эти быстро и упорно продвигаются вперед. Именно их попадание в яйцеклетку приводит к желанной (или нежеланной) беременности. В сперме 32% должны составлять именно они. «Прогрессивные» и «непрогрессивные» сперматозоиды вместе должны дать сумму в 40%.
Важно знать: именно этот показатель больше всего зависит от психического и нервного состояния пациента.

Строение сперматозоидов
Для того чтобы понять насколько форма (морфология) «хвостатых существ» соответствует норме, их рассматривают под микроскопом, увеличивая в 1000 раз. При этом препарат сначала окрашивают. Как выглядит полноценный сперматозоид?
Его головка овальная, гладкая, четкая. В ней 2 части. В одной — ферменты, без которых невозможно оплодотворение. Размер этой части занимает 40-70% объема всей головки. В другой части находится генетический материал. Шейка и жгутик (он в 10 раз длиннее головки) тоже имеют четкую форму. Любое отклонение может привести к затрудненному оплодотворению.
На что обратить внимание при прохождении исследования?
показания могут меняться с течением времени, а также в зависимости от состояния (физиологического и психологического) пациента;
- ВОЗ считает, что если исследование показывает 4% нормальных сперматозоидов, то мужчина способен иметь детей;
- показатели во многом зависят от того, насколько правильно пациент подготовился к анализам.
Как правильно подготовить себя к спермограмме?
Подготовка начинается не меньше чем за 4-5 дней до похода в лабораторию. В это время мужчина обязан:
- исключить из своей жизни любой алкоголь;
- воздерживаться от мастурбации и половых контактов;
- полностью отказаться о приема любых препаратов (кроме жизненно важных). О наличии последних следует сообщить врачу;
- не посещать бань, парилок и т.п.

Как правильно собирать и сдавать эякулят?
- лучше всего делать это не дома, а в помещении лаборатории. Любые температурные воздействия на сперму влияют на ее характеристики;
- категорически нельзя использовать презервативы: их смазка сильно влияет на кислотность спермы. Можно использовать только стерильную лабораторную посуду;
- собрать нужно всю сперму, особенно, первые ее капли;
- если сперма для анализа должна быть получена в процессе мастурбации, следует тщательно следить за чистотой рук и пениса и не использовать никаких смазок.
Спермограмма — это приговор?
Нет, это не приговор.
показания обеспечивают точность до 5%. Именно эти 5% могут быть решающими. Ведь оплодотворяет яйцеклетку всего 1 сперматозоид;
- данные меняются постоянно, поэтому нужно не менее 3-х раз (через каждые 2 недели) сдавать эякулят, чтобы получить более-менее точные значения;
- неправильная подготовка к спермограмме может исказить ее конечный результат.
Медицине известны случаи, когда мужчина с неблагоприятными показателями спермограммы становился отцом. И этому не всегда предшествовало медикаментозное лечение.
Мужское бесплодие может зависеть от деятельности головного мозга. Если представитель сильного пола боится или не хочет наступления беременности партнерши, мозг начинает блокировать производство полноценных сперматозоидов. Их количество может уменьшиться и под действием других навязчивых мыслей или страхов. Стоит только мужчине нормализовать свое душевное состояние, избавиться от отягощающих эмоций, как количество сперматозоидов и их качество становятся нормальными.
Именно поэтому, получив на руки спермограмму с «плохими» показателями, нужно не расстраиваться, а пройти курс лечения или психологической поддержки.

Точный анализ спермограммы и прогноз на будущее отцовство можно получить там же, где была проведена сдача анализов. Занимается мужской фертильностью врач уролог-андролог.
Вопрос-ответ
Как проверить мужчину на фертильность?
Спермограмма — анализ эякулята (спермы), используемый в медицине для установления фертильности мужчины и выявления возможных заболеваний половой системы. Спермограмму назначают при жалобах супружеской пары на бесплодие, также спермограмма показана донорам спермы и людям, планирующим криоконсервацию спермы.
Как понять, что у мужчины высокая фертильность?
Чаще всего мужское бесплодие вызывает неспособность сперматозоидов оплодотворить яйцеклетку. Выявить патологию можно с помощью спермограммы. Этот анализ позволяет определить количественный состав эякулята, а также морфологию и степень подвижности сперматозоидов.
Можно ли забеременеть с патологией головки?
Что такое патология головки? Патология головки – состояние, которое в большинстве случаев поддается лечению. Если устранить эту проблему под контролем врача-андролога, шансы на успешное зачатие и вынашивание ребенка значительно возрастают.
Сколько должна быть морфология, чтобы забеременеть?
Морфологически нормальные формы сперматозоидов (строгие критерии) ≥ 4 % или равно 4 %. Морфологически нормальный сперматозоид, который обладает наибольшим оплодотворяющим потенциалом, согласно этим критериям, имеет головку овальной формы с акросомой, занимающей 40-70 % от объема головки, и длинным ровным хвостом.
Советы
СОВЕТ №1
Перед сдачей спермограммы воздержитесь от сексуальной активности в течение 2-5 дней. Это поможет получить более точные результаты, так как за это время количество и качество спермы стабилизируются.
СОВЕТ №2
Избегайте употребления алкоголя, наркотиков и курения за несколько дней до анализа. Эти факторы могут негативно повлиять на качество спермы и искажать результаты исследования.
СОВЕТ №3
Обратите внимание на свое питание и уровень физической активности. Здоровый образ жизни, включая сбалансированное питание и регулярные физические упражнения, может значительно улучшить качество спермы.
СОВЕТ №4
Не забывайте о важности консультации с врачом. Если результаты спермограммы вызывают у вас беспокойство, обязательно обсудите их с квалифицированным специалистом для получения рекомендаций и возможного лечения.

 длина среднестатистического мужского сперматозоида — 55 мкм;
длина среднестатистического мужского сперматозоида — 55 мкм;
любое исследование имеет погрешность не менее 5%. По этой причине единожды сданная сперматограмма не может приниматься во внимание, какие бы показатели в ней не были указаны. Для получения более или менее точных результатов будущий отец должен пройти исследование трижды;
любое исследование имеет погрешность не менее 5%. По этой причине единожды сданная сперматограмма не может приниматься во внимание, какие бы показатели в ней не были указаны. Для получения более или менее точных результатов будущий отец должен пройти исследование трижды;

 показания могут меняться с течением времени, а также в зависимости от состояния (физиологического и психологического) пациента;
показания могут меняться с течением времени, а также в зависимости от состояния (физиологического и психологического) пациента;
 показания обеспечивают точность до 5%. Именно эти 5% могут быть решающими. Ведь оплодотворяет яйцеклетку всего 1 сперматозоид;
показания обеспечивают точность до 5%. Именно эти 5% могут быть решающими. Ведь оплодотворяет яйцеклетку всего 1 сперматозоид;



